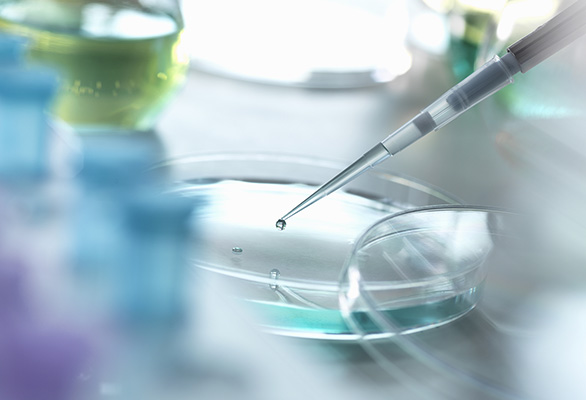

LATEST NEWS

 热门资讯
热门资讯-
【重磅合作】厦门赛伯乐尔生物科技有限公司 × 国创金融达成战略联盟!在健康中国战略全面推进的新时代背景下,厦门赛伯乐尔生物科技有限公司与国创金融正式达成里程碑式战略合作,共同发起设立大健康产业投资基金。此次合作将充分发挥赛伯乐尔"让生命无限可能"的创新理念与国创金融的资本优势,以前沿科技和金融资本双轮驱动,加速医疗健康领域的创新突破与产业升级。 让生命无限可能:…2025-04-24
-
共话军民融合,探索生命无限可能——退役军官代表团莅临赛伯乐尔参观交流4月17日,赛伯乐尔迎来了一批特殊的客人——来自退役军官的代表团。他们带着对前沿科技的关注和对生命科学的探索精神,走进赛伯乐尔,深入了解公司在细胞治疗与再生医学领域的最新进展,共同探讨军民融合背景下科技创新的未来方向。 上午10时,几位退役军人抵达赛伯乐尔总部,公司高层及团队热情接待。在参观环…2025-04-22
-
干细胞前沿资讯快报1. 诱导多能干细胞(iPSCs)的突破- 资讯:科学家们在iPSCs的生成和分化技术上取得了显著进展,能够更高效地将其转化为特定细胞类型,如心肌细胞、神经细胞等。- 应用:这些技术有望用于个性化医疗和疾病模型的研究。2. 干细胞在再生医学中的应用- 资讯:研究人员成功利用干细胞修复受损的心脏组织,并在动物实验中取得了…2025-03-10
-
干细胞可以应用在哪些领域干细胞因其自我更新和多向分化能力,在多个领域具有广泛应用前景。以下是主要应用领域:1. 再生医学- 组织修复:用于修复或替换受损组织,如心肌梗死后的心脏组织、脊髓损伤后的神经组织。- 器官再生:研究用于生成功能性器官,如肝脏、肾脏。2. 疾病治疗- 神经系统疾病:如帕金森病、阿尔茨海默病、脊髓损伤。- 心血管疾…2025-03-10
 致力于生命健康及抗衰保养的专业管理服务
致力于生命健康及抗衰保养的专业管理服务

-

-
在健康中国战略全面推进的新时代背景下,厦门赛伯乐尔生物科技有限公司与国创金融正式达成里程碑式战略合作,共同发起设立大健康产业投资基金。此次合作将充分发挥赛伯乐尔"让生命无限可能"的创新理念与国创金融的资本优势,以前沿科技和金融资本双轮驱动,加速医疗健康领域的创新突破与产业升级。 让生命无限可能:…
-

-
4月17日,赛伯乐尔迎来了一批特殊的客人——来自退役军官的代表团。他们带着对前沿科技的关注和对生命科学的探索精神,走进赛伯乐尔,深入了解公司在细胞治疗与再生医学领域的最新进展,共同探讨军民融合背景下科技创新的未来方向。 上午10时,几位退役军人抵达赛伯乐尔总部,公司高层及团队热情接待。在参观环…
-

-
1. 诱导多能干细胞(iPSCs)的突破- 资讯:科学家们在iPSCs的生成和分化技术上取得了显著进展,能够更高效地将其转化为特定细胞类型,如心肌细胞、神经细胞等。- 应用:这些技术有望用于个性化医疗和疾病模型的研究。2. 干细胞在再生医学中的应用- 资讯:研究人员成功利用干细胞修复受损的心脏组织,并在动物实验中取得了…
-

-
干细胞因其自我更新和多向分化能力,在多个领域具有广泛应用前景。以下是主要应用领域:1. 再生医学- 组织修复:用于修复或替换受损组织,如心肌梗死后的心脏组织、脊髓损伤后的神经组织。- 器官再生:研究用于生成功能性器官,如肝脏、肾脏。2. 疾病治疗- 神经系统疾病:如帕金森病、阿尔茨海默病、脊髓损伤。- 心血管疾…
-
-
干细胞制备是从不同来源获取并处理干细胞,使其适用于研究和治疗的过程。以下是主要步骤和来源:1. 来源- 胚胎干细胞(ESCs):来自早期胚胎的内细胞团。- 成体干细胞(ASCs):来自骨髓、脂肪组织、皮肤等。- 诱导多能干细胞(iPSCs):通过基因重编程将体细胞转化为多能干细胞。2. 提取- 胚胎干细胞:从体外受精的胚胎…
版权所有 © 厦门赛伯乐尔生物科技有限公司












